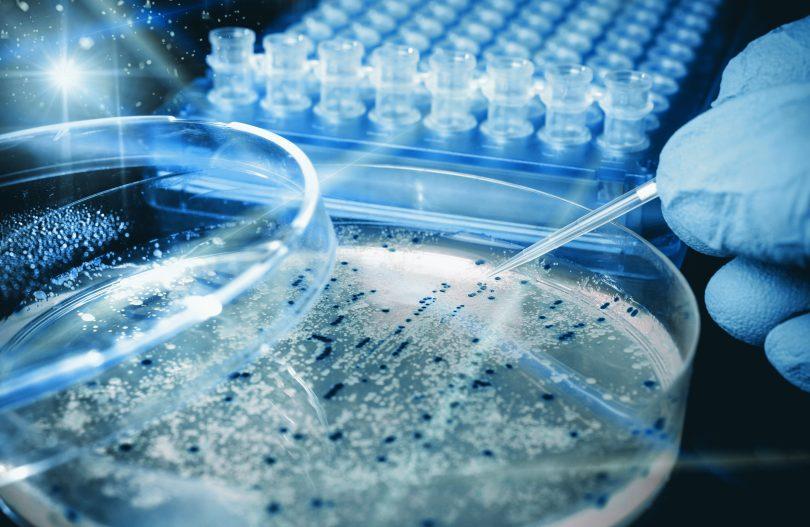

Sponsored
Boswellia Market Production Status, Growth and Demands 2024
The Boswellia Market Research focuses on the key trends prevailing in the global business sector. The existing Industry scenario has been studied and future projections with respect to the sector have also been investigated. Market study report comprises evaluation of numerous influential factors including industry overview in terms of recent developments in both historical and current situations, key companies, product/service application and types, key regions and market places, forecast estimation for global market share, revenue and CAGR. Boswellia Market Report is highly -intensive driven by high R&D investment and has strong product analysis to maintain growth and ensure long-term monetization with a forecast period of 2024-2030.
The Boswellia Market is anticipated to grow from USD 90.5 million in 2024 to USD 153 million by 2030, at a CAGR of 5% during the forecast period.
Download free sample report:
https://exactitudeconsultancy.com/reports/1073/boswellia-market/#request-a-sample
The record is an in-depth evaluation of a wealthy supply of essential elements that are accountable for the development of the global Boswellia market. The report splits the market length, through amount and value, based on application, type, and geography. The report profiles the important members in the enterprise, along with an itemized analysis in their positions against the global landscape.
Key players in the Boswellia market include:
Sabinsa Corporation, Arjuna Natural Extracts Pvt. Ltd., PLT health Solutions Inc., Alchem International Pvt. Ltd., Nutra Green Biotechnology Co. Ltd., Gurjar Pytochem Pvt. Ltd., S.A. Herbal Bioactives LLP, Alpspure Lifesciences Private Limited, Pharmanza Herbal Pvt. Ltd. and LAILA NUTRACEUTICALS.
Boswellia Market Segmentation:
Boswellia Market By Source 2019-2028, (IN USD Million)
Papyrifera
Sacra
Serrata
Cartetti
Boswellia Market By Application, 2019-2028, (IN USD Million)
Herbal Medicinal Products
Food Supplements
Personal Care Products
Aromatherapy
Others
Boswellia Market By Type, 2019-2028, (IN USD Million)
Resins
Essence Oils
Extracts
Geographical segmentation:
- North America (United States, Canada and Mexico)
- Europe (Germany, France, United Kingdom, Russia, Italy, and Rest of Europe)
- Asia-Pacific (China, Japan, Korea, India, Southeast Asia, and Australia)
- South America (Brazil, Argentina, Colombia, and Rest of South America)
- Middle East & Africa (Saudi Arabia, UAE, Egypt, South Africa, and Rest of Middle East & Africa)
The Study Objectives of the Boswellia Market are:
1. To investigate and explore the worldwide limit, creation, esteem, utilization, status, and conjecture.
2. Focus on key Boswellia manufacturers and study capacity, production, value, market share, and development plans for the coming years.
3. Focus on global key manufacturers, identify, describe and analyze the market competition environment, SWOT analysis.
4. Define, describe and predict the market by type, application, and region.
5. To examine the worldwide and key district’s market potential and benefit, opportunity and challenge, restrictions and dangers.
6. Identify key trends and factors that drive or hinder the Boswellia market growth.
7. To dissect the open doors on the lookout for partners by recognizing the high development sections.
8. To decisively dissect each submarket for individual development pattern and their commitment to the Boswellia market.
9. To separate forceful progressions, for instance, expansions, game plans, new thing dispatches, and acquisitions keeping watch.
10. To decisively profile the participants and thoroughly break down their development systems
Access full Report:
https://exactitudeconsultancy.com/reports/1073/boswellia-market
What to Expect From This Report on Boswellia Market
· You can make the developmental plans for your business when you have information on the value of the production, cost of the production, and value of the products, and more for the next five years.
· A detailed overview of regional distributions and the overview types of popular products in the Market.
· How do the major companies and mid-level manufacturers make a profit within the Market?
· Estimate the break-in for new players who want to enter the Industry.
· Detailed research on the overall expansion within the Boswellia Market that helps you decide the product launch and asset developments.
We offer customization on the Boswellia market report based on specific client requirements:
· 20% free customization.
· Five Countries can be added as per your choice.
· Five Companies can add as per your choice.
· Free customization for up to 40 hours.
· After-sales support for 1 year from the date of delivery.
Get More: https://exactitudeconsultancy.com/primary-research/
Thank you for your interest in the Boswellia Market research publications; you can also get individual chapters or regional/country report versions such as Germany, France, China, Latin America, GCC, North America, Europe or Asia.
Other Language Reports:
https://exactitudeconsultancy.com/ko/reports/1073/boswellia-market
https://exactitudeconsultancy.com/zh-CN/reports/1073/boswellia-market
https://exactitudeconsultancy.com/ja/reports/1073/boswellia-market
https://exactitudeconsultancy.com/fr/reports/1073/boswellia-market
https://exactitudeconsultancy.com/de/reports/1073/boswellia-market
About Us:
Exactitude Consultancy is a Market research & consulting services firm which helps its client to address their most pressing strategic and business challenges. Our professional team works hard to fetch the most authentic research reports backed with impeccable data figures which guarantee outstanding results every time for you. So, whether it is the latest report from the researchers or a custom requirement, our team is here to help you in the best possible way.
Contact: Exactitude Consultancy
Phone Number +1(704) 266-3234
Email Address: sales@exactitudeconsultancy.com
Check current updates: https://bulletin.exactitudeconsultancy.com
For more Information: https://www.analytica.global/
Categories
Read More
The Global White Biotechnology Market is witnessing unprecedented growth as industries worldwide embrace sustainable manufacturing processes and bio-based alternatives to conventional chemical products. Recent market analysis indicates that the white biotechnology market is projected to reach USD 324.5 billion by 2030, expanding at a remarkable CAGR of 9.7% from 2024 to 2030. Get...
Market Overview 2025-2033 The India facility management market size was valued at USD 2.58 Billion in 2024. Looking forward, IMARC Group estimates the market to reach USD 6.66 Billion by 2033, exhibiting a CAGR of 11.10% from 2025-2033.The India facility management market is driven by factors such as increasing urbanization, infrastructure development, and the growing demand for cost-effective...
